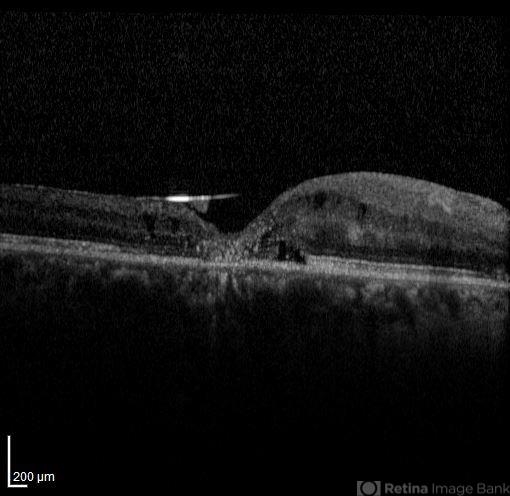

-
---thumb.jpg/image-square;max$48,0.ImageHandler) By Hamid Ahmadieh, MD
By Hamid Ahmadieh, MD
Labbafinejad Medical Center - Uploaded on Nov 14, 2013.
- Last modified by Hamid Ahmadieh, MD on Nov 15, 2013.
- Rating
- Appears in
- Miscellaneous
- Condition/keywords
- silicone oil, optical coherence tomography (OCT)
- Photographer
- Naghmeh Nozhat, Negah Eye Center, Tehran
- Imaging device
- Optical coherence tomography system
- Description
- OCT image of the silicone oil surface bridging an enhanced foveal depression. There is the history of a rhegmatogenous retinal detachment associated with full thickness macular hole repair.

Initializing download.
Initializing download.










